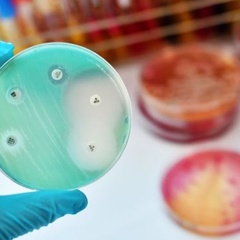

20 Mar 2020
Cambridge research team working towards vaccine against COVID-19

20 Mar 2020
World’s first artificial pancreas app licensed for people with type 1 diabetes in UK

20 Mar 2020
Inflammation in the brain linked to several forms of dementia

2 Mar 2020
Ground-breaking ceremony celebrates start of construction work on new Heart and Lung Research Institute in Cambridge

28 Jan 2020
Drug improves symptoms of autism by targeting brain’s chemical messengers

23 Jan 2020
Magnetised molecules used to monitor breast cancer

16 Dec 2019
Study highlights potential for ‘liquid health check’ to predict disease risk

5 Nov 2019
Regeneration mechanism discovered in mice could provide target for drugs to combat chronic liver disease

23 Oct 2019
University of Cambridge involved in £55m transatlantic alliance to research early detection of cancer

4 Oct 2019
Study highlights potential of whole genome sequencing to enable personalised cancer treatment

4 Oct 2019
Type 2 diabetes remission possible with ‘achievable’ weight loss, say researchers

18 Sep 2019
Nanoparticles used to transport anti-cancer agent to cells

13 Aug 2019
New stem cell combination could help to repair damaged hearts

11 Jul 2019
Cambridge Heart and Lung Research Institute receives major funding boost

1 Jul 2019
Widely-available antibiotics could be used in the treatment of ‘superbug’ MRSA